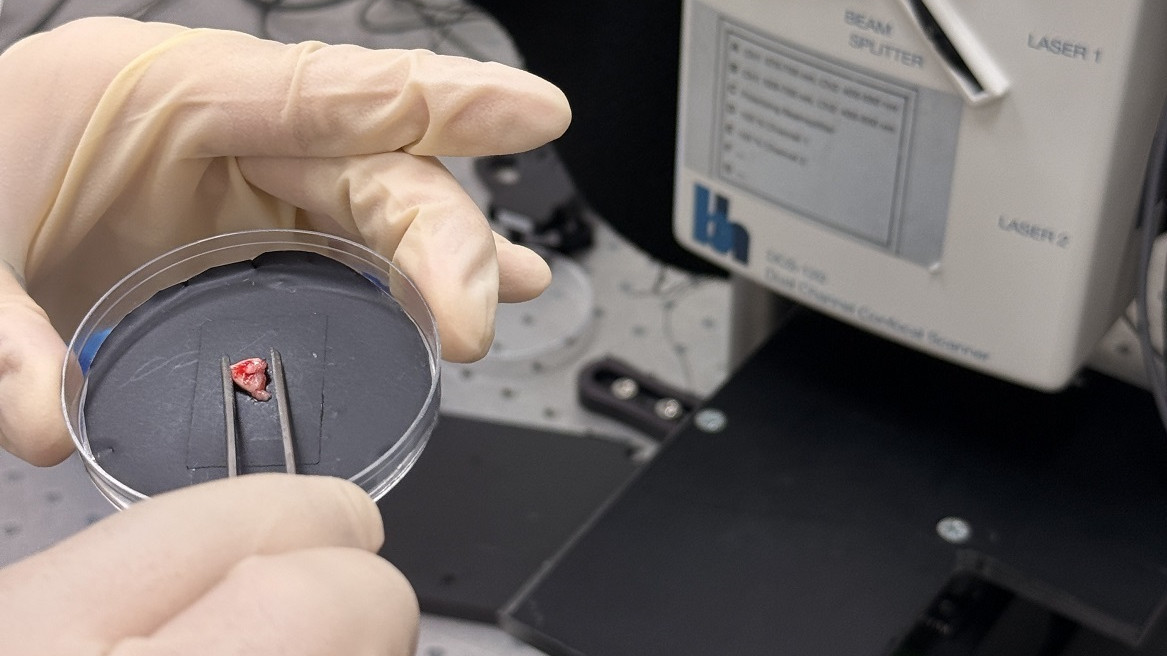

Российские ученые предложили высокоточный метод диагностики опухолей головного мозга
Ученые Приволжского исследовательского медицинского университета (ПИМУ) предложили технологию для высокоточной диагностики опухолей головного мозга. Метод, основанный на анализе флуоресценции – собственного свечения – тканей, позволил с точностью до 87% выявить новообразования и определить зоны инфильтрации – места, где раковые клетки проникают в окружающие здоровые ткани. Результаты исследования опубликованы в журнале Biomedical Optics Express.
Разработка поддержана грантом Российского научного фонда (РНФ) и поможет точнее определять границы злокачественных опухолей в головном мозге. Это поможет хирургам повысить эффективность их удаления.
Глиомы – наиболее распространенный тип опухолей головного мозга, который поражает вспомогательные клетки нервной ткани (глию). При этом, по статистике, от 50 до 90% глиом дают рецидивы, так как часто эти новообразования не имеют четкой границы: они прорастают в окружающие здоровые ткани, формируя так называемую зону инфильтрации, которую существующие методы диагностики способны определять недостаточно точно.
Российские ученые предложили использовать для диагностики глиом метод макро-FLIM. Он основан на том, что большинство тканей, в том числе нервная, под действием света определенных длин волн испускают собственное свечение (флуоресценцию). При этом, если внешний источник света выключить, флуоресценция еще какое-то время будет сохраняться. Именно длительность такого затухания сигнала исследователи отслеживают в рамках подхода макро-FLIM. Этот период, называемый временем жизни флуоресценции, отличается у нормальных и опухолевых клеток, а потому его можно использовать для диагностики.
Авторы исследовали образцы тканей головного мозга, взятые у 53 пациентов с глиомами. Образцы сканировали на конфокальном макросканере, который возбуждал флуоресценцию лазером и измерял время ее затухания в каждой точке снимка. Полученные «карты флуоресценции» анализировали вручную и с использованием алгоритма машинного обучения, подготовленного к работе с подобными изображениями.
Анализ показал, что метод макро-FLIM позволяет выявлять глиомы с точностью до 87%. Более того, с его помощью ученым удалось отследить зоны инфильтрации опухоли в здоровые ткани, что критически важно для точного хирургического удаления новообразований. В отличие от традиционного гистологического исследования, новый метод дает возможность обнаруживать участки опухоли в удаленном образце ткани прямо во время операции, кроме того, он не требует никакой пробоподготовки и специальной окраски срезов.
Исследователи планируют расширить выборку пациентов, улучшить точность автоматического распознавания опухолей и провести сопоставление изображений FLIM не только с их морфологическими, но и с молекулярными особенностями, рассказала участник проекта заместитель директора по науке НИИ экспериментальной онкологии и биомедицинских технологий ПИМУ Марина Ширманова.















Нет комментариев
Комментариев: